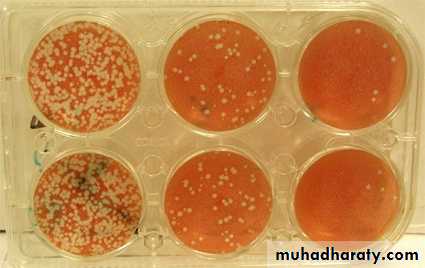

Cultivation, Detection and Quantitation of viruses
2nd lecture of Medical Virology for 3rd year studentsPresented by Dr. Mohammed J. M. Shallal
Many viruses can be grown in cell cultures or in fertile eggs under strictly controlled conditions. Growth of virus in animals is still used for the primary isolation of certain viruses and for studies of the pathogenesis of viral diseases and of viral oncogenesis.
Cultivation of Viruses
Viruses are causes many human diseases, including smallpox, flu, AIDS, and etc……
The primary purposes of virus cultivation are:
Techniques used in cultivating and identifying viruses:
Methods used for cultivation of virus
1- Lab. Animal Inoculation
Inoculation of virus in lab. animals
Advantages of Animal Inoculation
Disadvantages of Animal Inoculation
2- Inoculation into embryonated egg
Chorioallantoic Membrane (CAM):
Allantoic Cavity
Amniotic Sac:Advantages of Inoculation into embryonated egg
Disadvantages of Inoculation into embryonated egg
3- Cell Culture
Types of cell culture
1- Primary cell culture:2- Diploid cell culture (Semi-continuous cell lines)
Rhesus embryo cell strain
3- Continuous cell lines
They invariably have altered and irregular numbers of chromosomesAdvantages of cell culture
Disdvantages of cell cultureMultiplication of a virus can be monitored in a variety of ways:
1. Development of cytopathic effects, include cell lysis or necrosis, inclusion bodies formation, giant cell formation, and cytoplasmic vacuolization.2. Appearance of a virus-encoded protein, such as the hemagglutinin of influenza virus.
3. Adsorption of erythrocytes to infected cells, called hemadsorption, due to the presence of virus-encoded hemagglutinin (parainfluenza, influenza) in cellular membranes.
4. Detection of virus-specific nucleic acid by molecular-based assays such as PCR .
Detection of Virus-Infected Cells
uninfected
early infection
late infection
5. Viral growth in an embryonated chick egg may result in death of the embryo (eg, encephalitis viruses), Production of pocks or plaques on the chorioallantoic membrane (eg, herpes, smallpox, vaccinia), Development of hemagglutinins in the embryonic fluids or tissues (e.g., influenza).
In the course of viral multiplication within cells, virus-specific structures called inclusion bodies may be produced. They become far larger than the individual virus particle and often have an affinity for acid dyes (e.g., eosin). They may be situated in the nucleus or in the cytoplasm (poxvirus), or in both. In many viral infections, the inclusion bodies are the site of development of the virions (the viral factories).
Variations in appearance of inclusion material depend largely upon the tissue fixative used.
The presence of inclusion bodies may be of considerable diagnostic aid. The intracytoplasmic inclusion in nerve cells Negri body is pathognomonic for rabies.
Inclusion Body Formation
Inclusion Body Formation
Inclusion Body Formation
Cytoplasmic inclusion bodies (Negri bodies) in nerve cells infected with Rabies virus
Cytoplasmic inclusion bodies in cells infected with sheep pox virusInclusion Body Formation
Intranuclear inclusion bodies in cells infected with CMV (Owel’s eye)Cowdry bodies are eosinophilic or basophilic nuclear inclusions composed of nucleic acid and protein seen in cells infected with Herpes simplex virus, Varicella-zoster virus, and Cytomegalovirus.
Stained by : hematoxylin-eosin stain
1- Physical MethodsQuantitative nucleic acid-based assays such as:
The polymerase chain reaction (PCR) can determine the number of viral genome (infectious and noninfectious) copies in a sample.
Serologic tests such as radio-immunoassays (RIA) and enzyme-linked immuno-sorbent assays (ELISA) can be standardized to quantitate the amount of virus in a sample.
Certain viruses contain a protein (hemagglutinin) that has the ability to agglutinate red blood cells of humans or some animals.
Virus particles can be counted directly in the electron microscope by comparison with a standard suspension of latex particles of similar small size.
Quantitation of Viruses
2- Biologic Methods
End point biologic assays depend on the measurement of animal death, animal infection, or cytopathic effects in tissue culture at a series of dilutions of the virus being tested. The titer is expressed as the 50% infectious dose (ID50), which is the reciprocal of the dilution of virus that produces the effect in 50% of the cells or animals inoculated.The plaque assay is the most widely used assay for infectious virus. Monolayers of host cells are inoculated with suitable dilutions of virus and after adsorption are overlaid with medium containing agar or carboxymethylcellulose to prevent virus spreading throughout the culture. After several days, the cells initially infected have produced virus that spreads only to surrounding cells produce a small area of infection, or plaque. Under controlled conditions, a single plaque can arise from a single infectious virus particle, termed a plaque-forming unit (PFU) be counted macroscopically.
PLAQUE ASSAY
PLAQUE ASSAY
15
PLAQUE ASSAY
PLAQUE ASSAY16
PLAQUE ASSAY
PLAQUE ASSAY17
Diluted 10 fold
Diluted 100 foldDiluted 1000 fold
18
Diluted 10 fold
Diluted 100 fold
Diluted 1000 fold
Pocks formation: certain viruses, eg, herpes and vaccinia, when inoculated onto the chorio-allantoic membrane of an embryonated egg can be quantitated by relating the number of pocks counted to the viral dilution inoculated.